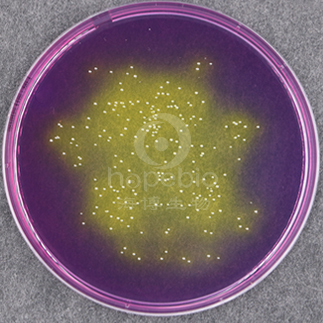
溴甲FEN紫平板计数琼脂培养基（BCP）
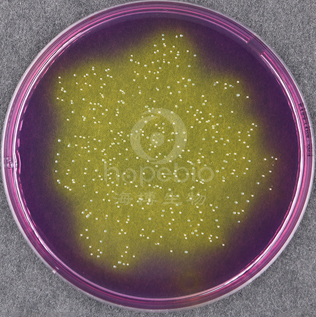
溴甲FEN紫平板计数琼脂培养基（BCP）

相关产品推荐更多 >
万千商家帮你免费找货
0 人在求购买到急需产品
- 详细信息
- 文献和实验
- 技术资料
- 库存:
999
- 英文名:
Bromocresol purple Plate Count Agar Medium
- 保质期:
三年
- 供应商:
青岛海博生物
- 规格:
瓶
用途:用于活乳酸菌菌落总数测定。
原理:
酵母浸粉、胨提供氮源、维生素、生长因子;葡萄糖为可发酵糖类;聚山梨酯80和半胱氨酸为培养各种乳酸菌提供生长因子,其成分还能抑制某些杂菌并中和细胞毒性物质,为乳酸菌提供一个良好的生长环境;琼脂是培养基的凝固剂。
成分(g/L):
酵母浸粉2.5
胨5.0
葡萄糖1.0
聚山梨酯801.0
半胱氨酸0.1
溴jia酚紫0.06
琼脂20.0
pH值6.8-7.025℃
用法:
称取本品29.66g,加热溶解于1000ml蒸馏水中,分装,115.5℃高压灭菌30分钟,备用。
不同细菌能在溴甲fen紫平板计数琼脂培养基(BCP)上的生长特征:
植物乳杆菌黄色菌落,菌落周围变黄
嗜酸乳杆菌菌黄色菌落,菌落周围变黄
溴甲fen紫平板计数琼脂培养基(BCP)微生物灵敏度试验:
按标签用法制备培养基,接种以下质控菌株,放置36℃需氧培养48小时。


风险提示:丁香通仅作为第三方平台,为商家信息发布提供平台空间。用户咨询产品时请注意保护个人信息及财产安全,合理判断,谨慎选购商品,商家和用户对交易行为负责。对于医疗器械类产品,请先查证核实企业经营资质和医疗器械产品注册证情况。
文献和实验【材料】 伤寒杆菌,甲、乙型副伤杆菌,痢疾杆菌诊断血清,载玻片,生理盐水等。【方法与结果】 根据初步鉴定结果,用已知诊断血清作玻片凝集试验,如发生凝集,即可确定。如疑集阴性,应复查后再定。 (二)继续鉴定:根据需要可进一步作生化反应,血清学分型等鉴定。 【注意事项】 1. 作分离培养时宜取脓血便接种于鉴别培养基或选择培养基上。 2. 挑取可疑菌落时,每份标本可选取2~3个菌落,每个菌落接种一支双糖管。 3. 玻片
苯基)-5-(2,4-二磺酸苯)-2H-四唑单钠盐],它在电子载体1-甲氧基-5-甲基吩嗪 硫酸二甲酯(1-Methoxy PMS)的作用下被细胞线粒体中的脱氢酶还原为具有高度水溶性的黄色甲 染料(Formazan dye)。生成的甲 物的数量与活细胞的数量成正比,因此可利用这一特性直接进行细胞增殖和毒性分析。CCK-8试剂中已预先配入了进行细胞增殖和毒性分析所需的成分,无需再用缓冲液或培养基进行稀释;同时,CCK-8试剂无需任何放射性同位素和有机溶剂。因此,无需特别的技巧,就可使每一位使用者准确、快速
出来才能对它进行研究、鉴定和应用。 一、接种与分离方法 根据待检标本的性质、培养目的和所用培养基的种类,采用不同的接种方法。 1.平板划线分离培养法 对混有多种细菌的临床标本,采用划线分离和培养,使原来混杂在一起的细菌沿划线在琼脂平板表面分离,得到分散的单个菌落,以获得纯种。临床送检的标本如痰、咽试子、泌尿生殖道的分泌物和粪便等细菌检验均需要借助琼脂平板划线分离目的菌。平板划线分离法通常有两种方法: (1)分区划线分离法:此法常用于含菌量较多的标本如痰、泌尿生殖道的分泌
技术资料暂无技术资料 索取技术资料










